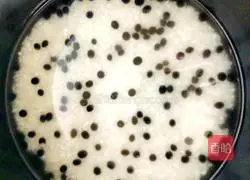
Black bean rice recipe 6

Health benefits
Black beans: strengthen the spleen
Ingredients
Black beans ( 80g ) | Rice ( 200g ) |
How to make black bean rice

1.Put the black beans into a bowl and set aside

2.Put the black beans into the rice cooker

3.Put the rice into a bowl and set aside

4. Pour the rice into the rice cooker

5.Add water and wash thoroughly
6.Add appropriate amount of water

7.Plug in the power, close the lid, and press the rice cooker function

8.Prepared black bean rice

9. Stir evenly with chopsticks

10.Prepared black bean rice
Tips
Soak the black beans for four hours in advance, and the steamed rice will be soft and delicious.
Copyright Statement:This article is a reprinted article, and the copyright belongs to the original author. Please retain the source when reprinting!







